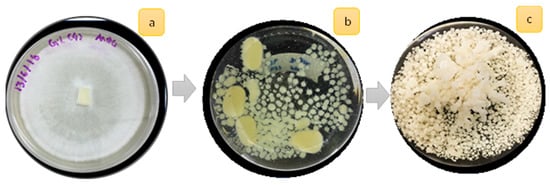

Abstract
Mycoremediation, a fungal-based technology, has seen tremendous growth as an effective alternative to treat industrial wastewater due to its ability to oxidise pollutant loadings. Considering the non-toxic properties and high potential degradation performance of Ganoderma lucidum, this research aims to study the performance of a Malaysian G. lucidum strain, the effect of agitation speed, and different carbon-to-nitrogen (C/N) ratio concentrations of synthetic wastewater in degrading chemical oxygen demand (COD) and ammonia. Different agitation speeds (25 rpm, 50 rpm and 100 rpm) and C/N ratios (C10N1, C13.3N1 and C16.7N1) were chosen as parameters to be analysed in this study. The best degradation of COD and ammonia with a percentage removal in the range of 95% to 100% within 30 h of treatment. ANOVA analysis was done using the response surface methodology to verify the obtained results, and it was found that mycoremediation using 100 rpm agitation provided the best results, removing more than 95% of COD and ammonia from synthetic wastewater. The microscopic analysis also showed that the structure of G. lucidum changed after wastewater treatment. This result proved that the Malaysian G. lucidum strain has a good potential in treating synthetic domestic wastewater, especially with high organic content, as a naturally sustainable bioremediation system.
1. Introduction
Over the years, an increase in the human population, improved lifestyles, and climate change in Malaysia have caused the domestic wastewater to have less quality, and patterns of pollutants are dynamic and unpredictable. This needs to be improved in treating highly contaminated domestic wastewater. When domestic wastewater is treated inefficiently, the contaminants, especially ammonia, can be discharged from sewage treatment plants (STP) to water bodies (rivers) and can cause a threat to human health and the river’s ecosystem. As described by Ariffin and Sulaiman in [1], 80% of domestic wastewater in developing countries such as Malaysia is released without proper treatment, polluting rivers, lakes, and coastal areas. The presence of ammonia can lead to problems in the taste and odour of water, increasing toxicity for aquatic life, oxygen depletion, and eutrophication [2].
Some conventional treatments that are commonly used are coagulation–flocculation, chemical precipitation, ion exchange, adsorption, membrane filtration, electrochemical treatment and biological treatment using bacteria [3]. Other than that, activated carbon is also commercially available and widely used in adsorption due to its high surface area, microspore structure, high adsorption capacity and high level of surface reactivity [4]. However, it is expensive, and its use is limited to a large scale, which is found in sewage treatment plants. Cheaper alternative treatments such as oxidation ponds and lagoons are commonly in use, but such treatments show low adsorption capacity [5]. Biological treatments, especially using bacteria, depend on pH, temperature, oxygen and nutrient composition for growth [6]. Generally, wastewater treatment is also bacteria-based, which involves a specific treatment type (i.e., nitrification and denitrification process) and is less suitable for complex wastewater characteristics which usually contain various cocktails of contaminants such as soap water from residents, various types of chemicals extracted from industries, wastes that are released during agriculture, and so on. Furthermore, most of the complex wastewater also contains protein, and many components, such as particles and fats, are also present [7].
In addition, due to the low wastewater concentration, conventional biological treatments require additional nutrients to optimise nutrient balance and maintain microbial activity to achieve optimal processes. The essential nutrients are carbon (C), nitrogen (N) and phosphorus (P), where maximum activity in aerobic wastewater treatment requires a C:N:P ratio to be maintained between 100:5:1 and 100:10:1 [8]. The average C/N ratio for domestic wastewater collected is in the range of 12 to 16. However, in places with high infiltration (such as tropical countries), the C/N ratio may be low (C/N < 4), according to the study by Tabassum et al. [9]. Due to the low strength characteristics of wastewater, bacterial-based wastewater treatment requires additional nutrients to optimise nutrient balance and maintain microbial activity to achieve optimal processes.
The use of fungi, especially Ganoderma lucidum (G. lucidum) from the Basidiomycetes family and White Rot Fungi (WRF) collection, could be the best wastewater treatment alternative because it can perform better in degrading the mixture of pollutants found in complex wastewater [10]. G. lucidum is a Chinese medicinal mushroom and its biomass has many biological, health-preserving and therapeutic effects [11,12,13]. Because G. lucidum can degrade complex pollutants such as chemical oxygen demand (COD) and ammonia, mycoremediation could provide a better alternative to remediate highly polluted wastewater. The WRF usually consists of complex enzymatic machinery such as ligninolytic enzymes, organic acids, mediators, and accessory enzymes that are non-specific due to their action via the generation of free radicals [14,15]. The G. lucidum biomass consists of the mentioned enzymes, which have the ability to break down complex pollutants in wastewater such as textile dyes [16] and pharmaceutical compounds [17].
A number of studies have been reported on successful fungi application in treating industrial wastewater, such as in the textile industry, with 52.41 to 78.12% of colour being removed in treatment using the fungal strains Aspergillus flavus and Fusarium oxysporium [18], and of pharmaceutical waste being removed from hospital wastewater by pellets of the fungal strain Trametes versicolor with an efficiency of 69 to 76%; the compound was reduced [19] and averaged a reduction of about 76% of pharmaceuticals in research by Lucas et al. [20] using the same strain of fungal. In the application of domestic wastewater, in a recent experiment performed by Hanafiah et al. [21], G. lucidum was used in the treatment of various concentrations of synthetic domestic wastewater. The finding showed that the C/N ratio of C17.8N1 wastewater had the best COD and ammonia removal compared to the lower C/N ratio. The shortest treatment time was in an acidic environment at pH 4, and the maximum COD and ammonia reductions were 96% and 93.2%, respectively. Based on the excellent performance of the Serbian strain, it is anticipated that the Malaysian strain of G. lucidum will have the same benefits, if not more, considering that the strain grows in the local climate.
Malaysia is one of the main countries that cultivate G. lucidum in mass production, and the research has grown adequately in recent years. Sectors such as medicine, food industry, aquaculture and bioremediation are involved in studying G. lucidum uniqueness. In addition, according to a recent study, G. lucidum is widely available in Malaysia and the locally pre-grown G. lucidum-biomass-EPS is considered a high-end material with high potential as an aquaculture feed [22]. In another study, Malaysian G. lucidum was evaluated for its antimicrobial efficacy. The G. lucidum crude polysaccharide extract showed beta-glycosidic linkages identifying them as β-glucan. Aside from that, the β-glucan of Malaysian G. lucidum showed a positive inhibition zone against Escherichia coli (E. coli), S. marcescens, S. aureus and S. epidermis, which has relevance to human health and foodstuffs [23].
This study introduces the Malaysian G. lucidum as a fungal treatment technology with COD and ammonia removal efficiencies to determine the difference between Serbian and Malaysian G. lucidum. The mycoremediation is stable enough to withstand extreme conditions and sustain the fluctuations of current wastewater characteristics. In the plan for a centralised wastewater treatment plant, the study was to academically evaluate the G. lucidum performance in synthetic domestic wastewater. To enhance the mycoremediation process, the present study was undertaken to assess the influence of different agitation speeds for the fungal treatment of synthetic wastewater in a batch reactor.
2. Materials and Methods
2.1. Preparation of Malaysian Ganoderma Lucidum Inoculum
The Ganoderma lucidum was obtained from the University Malaya, Kuala Lumpur, Malaysia. The mycelial pellets production was done as previously described by Supramani et al. [24] and shown in Figure 1. The first seed culture was prepared using four mycelia agar squares from a 10-day-old plate and was inoculated into a 500 mL Erlenmeyer flask containing 100 mL of liquid medium. The composition of the liquid medium for pellet growth was glucose (30 g/L); potassium phosphate, KH2PO4 (0.5 g/L); di-potassium phosphate, K2HPO4 (0.5 g/L); magnesium sulphate, MgSO4 (0.5 g/L); yeast extract, YE (1 g/L); and ammonium chloride, NH4Cl (4 g/L). The cultivation was carried out at 30 °C with pH maintained at 4.0 and shaken at 100 rpm for 11 days, according to the optimum procedure suggested by Wan-Mohtar in [23,24]. After 10 days, mycelium from the first seed culture was homogenised using a sterile Waring blender for 20 s to create extra growing hyphae tips. Then, it was used as inoculum for the second seed culture in a 500 mL Erlenmeyer flask containing 200 mL medium and transferred to the bioreactor using the same medium as the first seed culture. The mycelium pellet is separated from the liquid media and is ready to inoculate into the bioreactor.
Figure 1.
Preparation of GLMP. (a) Mycelium on agar plate after day 10. (b) First seed production. (c) Second seed production at day 10.
2.2. Experimental Setup
To avoid the dynamic interaction of microorganisms in real wastewater, this study utilised synthetic wastewater to mimic the real wastewater at different concentrations of organic content. The bioreactor (each 1000 mL in size) was set up to determine the performance of Malaysian G. lucidum in treating domestic wastewater in lab-scale reactors. Different concentrations of synthetic domestic wastewater samples were prepared for a working volume of 1000 mL, as illustrated in Figure 2.

Figure 2.
Batch reactors set up for the synthetic domestic wastewater using Malaysian G. lucidum; A, B refer to C10N1; C, D refer to C13.3N1 and E, F refer to C16.7N1.
The solutions of glucose were prepared to give a varying carbon concentration (defined as COD) at 300, 400 and 500 mg/L, and a constant concentration of ammonia of 30 mg/L were prepared for each reactor to make the COD to Nitrogen ratio (COD/N) of C10N1, C13.3N1 and C16.7N1, as shown in Table 1. The composition of synthetic wastewater was prepared according to recipe [21]; glucose (300, 400 and 500 mg), ammonium chloride, NH4Cl (73 mg); di-sodium phosphate, Na2HPO4 (15 mg); potassium phosphate, KH2PO4 (1.5 mg); calcium chloride, CaCl2 (4 mg); and magnesium sulphate, MgSO4 (2 mg). To let the G. lucidum grow better and to avoid fungal deposition at the bioreactor’s surface, each bioreactor was supplied with aeration (3 L/min) to create an aerobic environment and maintained that level until the end of the treatment. The initial pH of the synthetic wastewater was between 6.5 to 7.5. Each reactor was inoculated with the same amount (0.1%) of fungal pellet, approximately 1.0 g of the pellet’s wet weight.

Table 1.
The composition of glucose, concentration COD, ammonia and the C/N ratio.
2.3. Operation Conditions
The experiment was carried out for 48 h and the performance of G. lucidum pellets treating the pollutants in wastewater was monitored consistently until the end of the experiment. From each reactor, 15 mL of sample volume was withdrawn using a pipette and pH was recorded using a pH meter (pH 300, Eutech, Thermo Scientific, Singapore) at treatment time (T0, T6, T12, T24, T30, T48). The samples were filtered using cellulose nitrate membrane filters (Whatman, Maidstone, UK) pore diameter size 0.45 µM). Physiochemical analyses were carried out on filtered samples to identify the percentage of pollutant removal.
The analysis method to measure the COD and ammonia (NH3-N) concentrations uses standard protocol from the manufacturer [25,26], respectively. It is a colourimetric method using the HACH vial high-range reactor digestion method (20–1500 mg/L) for COD and the Salicylate Method, low range (0.01–0.50 mg/L), for NH3-N. The colour development was measured by using the UV Spectrophotometer HACH DR6000 under the stored program 435 COD HR and 385 N, Ammonia. Salic (HACH, Kuala Lumpur, Malaysia). The reactors were prepared in duplicate, and the average and SD were calculated for the analysis result and are presented in the results and discussion section.
2.4. Calculations and Statistical Analysis
The percentage removal of the COD and NH3-N was calculated based on Equation (1) [27], where Xi is the initial concentration of COD or NH3-N and Xf is the temporal concentration of COD and NH3-N.
Based on the experimental data, the statistical analysis was conducted using Response Surface Methodology (RSM). The central composite design used in RSM uses Design Expert@Version 13, Stat-Ease, Inc., (Minneapolis, MN, USA) to calculate ANOVA for each set experiment. To determine ANOVA, the response function (Y) has been divided into quadratic, linear and interactive components, and data from the test were accepted to the regression equation, as presented in Equation (2).
The Y states as the expected response, β0 is the intercept, βi, βii and βij are the linear, quadratic and interaction and Xi and Xj are the variables levels. The confidence level of 95% was used to calculate significance level. The quality of the fit of the model was expressed by the determination coefficient (R2).
2.5. Image Analysis
The morphological changes on the G. lucidum pellets were observed under a light microscope (Labomed, Los Angeles, CA, USA) connected to a digital camera (iVu 1500) and a Field Emission Scanning Electron Microscope (FESEM), Model SUPRA 55VP (CARL ZEISS, Jena, Germany). The pellets before and after treatment were dried under 35 °C using a food dehydrator for 2 h to ensure no moisture content in the sample prior to analysis.
3. Results and Discussion
3.1. The Effectiveness of Malaysian Ganoderma Lucidum
The effectiveness of Malaysian G. lucidum was investigated using the lowest speed agitation at 25 rpm followed by 50 rpm and 100 rpm at a consistent COD/N ratio of synthetic wastewater. The lowest agitation speed was chosen to study the feasibility of treating G. lucidum pellets at the lowest agitation to minimise the operating costs and to compare the pollutant removal performance at the same COD/N ratio as experiments using higher agitation. Even though a more heightened agitation will increase the operation cost, it technically provides adequate mixing, mass, and heat transfer. It improves the dissolved oxygen in the reactors to promote nutrient uptake by G. lucidum, subsequently shortening treatment time. Furthermore, higher agitation was chosen because during the growth phase the optimal agitation speed was 100 rpm, as discovered in previous work done by [24].
Figure 3 and Figure 4 show the percentage removal of COD and ammonia in C10N1, C13.3N1, and C16.7N1 at different agitation speeds, respectively. Initially, the pH of each reactor was set as it is (in the range between 6.5 and 7.5) and calculated as an average being plotted in the same graph (black line). Gradually, the pH reduced to a range between 2.9 and 3.5, and the percentage removal for COD and ammonia subsequently increased, showing a reduction of the pollutant concentration in the reactors efficiently at acidic pH. Most fungi are determined to have optimum pH below 5.0 [28] for the mycoremediation application. Some fungi can also be effective in other ranges of pH, such as in a study performed by Dalecka et al. [29] which showed that fungi A. luchuensis removed diclofenac from wastewater at a pH of 7.8, compared to fungal strain T. versicolor, which showed a higher removal of diclofenac at an acidic pH of 5.5.

Figure 3.
Graph of percentage removal (±standard deviation) of COD for the sample C10N1, C13.3N1 and C16.7N1 at (a) 25 rpm, (b) 50 rpm, and (c) 100 rpm.

Figure 4.
Graph of percentage removal (±standard deviation) of NH3-N for the sample C10N1, C13.3N1 and C16.7N1 at (a) 25 rpm, (b) 50 rpm, and (c) 100 rpm.
Different COD/N ratios did not show visible significant differences in percentage removal at the end of treatment. In the slower sets experiment (25 rpm), the lower COD/N ratio (C10N1) gives the lowest percentage of removal at the end of treatment with 75% compared to the higher COD/N ratio (C13.3N1 with 87.7% and C16.7N1 with 94%). A similar pattern was revealed in ammonia removal; the C10N1 observed had the lowest percentage removal (67%) followed by C13.3N1 (83%) and C16.7N1(100%). A higher COD/N ratio gives a higher percentage of removal compared to a lower COD/N ratio due to sufficient nutrient composition to be utilised by the biomass G. lucidum, consequently leading to a higher percentage removal.
However, the low percentage removal at a low COD/N ratio improved when the agitation increased to 50 rpm and 100 rpm. In the set of experiments at 50 rpm, at the end of treatment time the percentage removal for COD was 90.7% (C10N1), 91.8% (C13.3N1), and 92.6% (C16.7N1); and percentage removal for ammonia was 72.2% (C10N1), 80.4% (C13.3N1), and 100% (C16.7N1). The percentage further improved in the 100 rpm set of experiments with 93.6% (C10.0N1), 95.8% (C13.3N1) and 95.2% (C16.7N1) for COD and 86.4% (C10N1), 93.8% (C13.3N1), and 100% (C16.7N1) for ammonia. The agitation improved the pollution uptake by the fungal pellet due to the homogenisation of the pellet in the reactor.
According to Seth and Chand [30], up to a certain mixing rate, the process can also reduce or lower enzyme production. The shear forces among the pellets also developed at a higher rate of mixing, and finally the nutrient (pollutant) uptake was reduced due to the cell damage effect from pellet collision [31]. The observation at the first 12 h of the treatment time in the lower agitation reactors (25 rpm) shows better percentage removal compared to the reactors at 50 rpm and 100 rpm. Gentle agitation provided better acclimatisation conditions for the biomass to adapt to the new environment, thus taking the pollutant (COD and ammonia) faster than at high agitation speeds.
3.2. Statistical Analysis
The statistical analyses were carried out to determine the relationship between the factors (COD/N ratio and treatment time) and response variables (COD and ammonia). Thus, three models were run based on agitation at the speeds of 25 rpm (Model 1), 50 rpm (Model 2) and 100 rpm (Model 3).
The result for Model 1 is shown in Table 2. The ANOVA analysis for COD and NH3-N data shows that the model is significant with the F-value for COD being 16.29 and NH3-N being 9.51. There is only a 0.01% (COD) and 0.07% (NH3-N) chance that the F-value occurs due to noise. The p-value less than 0.0500 (p < 0.05) indicates the model terms are significant; a value greater than 0.1000 indicates that the model term is not significant and a B value less than 0.1000 indicates the term is significant. The AB shows a p-value of 0.2805 (COD) and 0.7143 (NH3-N), which is not significant because the reduction percentage does not show a significant difference throughout the treatment time. The statistical fit in Table 2b shows the predicted R2 of 0.7137 (COD) and 0.5256 (NH3-N) is in reasonable agreement with the adjusted R2 of 0.8181 (COD) and 0.7145 (NH3-N); that is, the difference is less than 0.2. A R2 value close to 1 is desirable and should be at least 0.80 to be considered a suitable model, while R2 values smaller than 0.75 indicate an insufficient description of the experimental data by the model.

Table 2.
Model 1 ANOVA analysis for degradation of COD and NH3-N in wastewater at 25 pm.
Based on Table 3, ANOVA analysis for the COD and NH3-N dataset for Model 2 showed that the model is significant. The F-value for Model 2-COD and -NH3-N is 25.61 and 61.03, respectively. A p-value less than 0.0500 indicates the model terms are significant. In this case, B, B2, for COD and A2, B2 for NH3-N are significant model terms. AB is not significant; 0.8928 (COD) and 0.2442 (NH3-N) show that the pellet in this experiment does not affect the removal of pollutants from wastewater. Pellets that are used in this set of experiments may not be in the active phase. Pellets that exceed the active phase usually utilise those nutrients in synthetic wastewater at a minimum level and take a long time to degrade COD and NH3-N [30]. The statistical fit in Table 3b shows the predicted R2 of 0.7992 (COD) and 0.9094 (NH3-N) are in reasonable agreement with the adjusted R2 of 0.8602 (COD) and 0.9375 (NH3-N); that is, the difference is less than 0.2.

Table 3.
Model 2 ANOVA analysis for degradation of COD and NH3-N in wastewater at 50 pm.
Based on Table 4, ANOVA analysis for Model 3 shows that the model is significant. The F-value for model 3-COD and -NH3-N is 91.89 and 44.48. A p-value less than 0.0500 indicates that the model terms are significant. In this case, A2 and B2 for COD and NH3-N are significant model terms. A value greater than 0.1000 indicates that the model term is not significant. AB for NH3-N shows 0.2779, which is not significant, because the removal of NH3-N at the end of this treatment shows approximately the same difference. The pattern of NH3-N removal in this experiment shows ups and downs and is not consistent. Inconsistent removal occurs due possibly to the pellets remaining in the adaptation phase, causing good removal to occur after 24 h [21]. The statistical fit table (Table 4b) shows the predicted R2 of 0.9493 (COD) and 0.8987 (NH3-N) is in reasonable agreement with the adjusted R2 of 0.9578 (COD) and 0.9158 (NH3-N); that is, the difference is less than 0.

Table 4.
Model 3 ANOVA analysis for degradation of COD and NH3-N in wastewater at 100 pm.
3.3. Microscopic Image Analysis
The characteristic of the morphology of the pellet in a submerged grown culture can show the capability of enzyme production of the fungus to subsequently affect the reactor’s performance [32]. Generally, the typical growth pattern of filamentous fungi in liquid media is in the form of cannular filaments called hyphae [31]. According to Schmideder et al. [33], each strain of a fungal pellet will show different morphologies; the compactness of hyphae affect the utilisation of nutrient and oxygen uptake in the media they are grown in. Thus, in the current study of the removal of COD and NH3-N from synthetic wastewater, treatment interaction was performed and observed under a light microscope (LM) and scanning electron microscopy (SEM). Figure 5 shows the LM image under magnifications x4 and x100, and Figure 6 shows the SEM image of the same pellet under magnification x3000 and x5000.

Figure 5.
Image under light microscope (LM) x4 and x100 magnification (a) before treatment—black arrow show transparent pellet and blue arrow show regular hairy hyphae and; (b) after treatment with initial C16.7N1—yellow arrow darker colour of pellet body and green arrow show hyphae less visible.

Figure 6.
Morphology observation on Malaysian G. lucidum pellet changes under FESEM. (a) Before treatment. (b) After treatment with an initial COD:N of 16.7:1; purple arrow show the hyphae tip network.
Macro-observation under x4 magnification showed the pellet before treatment (Figure 5a) was transparent (black arrow), round-shaped, had regular hairy hyphae (blue arrow), and was spherical or symmetrical. A further increase of magnification to x100 showed the dense network of the branched hyphae formed during the cultivation. After treatment (Figure 5b), the pellet was still visible, with a compact spherical shape and oval masses; however, they became darker (yellow arrow) and not transparent, possibly due to the absorption of the NH3-N contaminant. The regular hairy hyphae around the pellet after treatment became less visible (green arrow). In the observation image under x100 magnification, the branched hyphae network became less dense than before treatment.
Micro-observation of the pellet before treatment (Figure 6a) showed a compact and dense hyphae tip network agglomerate, indicating that healthy pellets with network space structure also pack together, and a regular shape of hyphae tip network (purple arrow). The network space structure shows a porous irregular surface, shown by the green arrow. The irregular shape of the hyphae tip network formed indicates the effect of the nutrient having been uptake by the pellet after treatment with the synthetic wastewater. After the treatment, the hyphae tip network shrank, and the link was less compact on the pellet surface.
3.4. Ganoderma Lucidum in Wastewater Treatment
A comparison of current work on Malaysian G. lucidum was made with the previous work done on Serbian G. lucidum treating synthetic domestic wastewater by [21]. Two concentrations of synthetic wastewater of COD/N 13.3:1 and 16.7:1 in 100 rpm with treatment times of 24 h and 48 h were taken for the purpose of discussion. The difference from the previous work was in the initial pH of the synthetic wastewater prepared before starting the treatment, which was pH 6.5 to 7.5 in the current work; the previous work initially set it at pH 4. Figure 7 shows the comparison of percentage removal between the two strains of G. lucidum. After 24 h treatment, Serbian G. lucidum showed a higher removal percentage than Malaysian G. lucidum for both parameters COD and ammonia in all reactors. The current work was about 20 to 50% less than Serbian G. lucidum due to non-adjustable pH in the initial treatment. Adjustment of pH in the initial treatment reduced the acclimatisation of the fungal pellet, thus increasing the percentage of COD and ammonia in 24 h.

Figure 7.
Comparison percentage between Serbian and Malaysian Ganoderma lucidum (Gl).
Nonetheless, in 48 h the percentage removal for COD and ammonia in the current work achieved a maximum percentage, as did Serbian G. lucidum. The current experimental work indicated that the potential of self-acclimatisation of G. lucidum in treating COD and ammonia in synthetic wastewater has a similar potential to that of Serbian G. lucidum culture. Locally grown G. lucidum culture can be utilised in bioremediation media for degradation of organic and nutrient in polluted water, is more suitable based on the local climate, and has a more promising performance than non-local strains.
Previous literature on the performance of G. lucidum and WRF fungi in treating different types of wastewater are shown in Table 5. In general, most of the WRF efficiently reduced the targeted pollutant. The conducted previous study used different types of WRF strains, such as Trametes versicolor (T. versicolor), G. lucidum, Irpex lacteus and Phanerochaete chrysosporium from different type of wastewater, such as synthetic and real industrial wastewater [34], synthetic wastewater spiked with selected pharmaceutically active compounds (PhACs) [35], synthetic domestic wastewater [36] and synthetic oil refinery wastewater [37].

Table 5.
Comparison of current work on white rot fungi (WRF) as mycoremediation in wastewater treatment.
In a treatment to remove pharmaceutically active compounds (PhACs) using few types of strains, Lucas et al. [35] found that 44 to 75% of the studied compounds (carbamazepine, diclofenac, iopromide and venlafaxine) were successfully removed during the treatment. In another study, WRF of T. vesicolor was studied by Zahmatkesh et al. [34] in synthetic and real industrial wastewater to eliminate humic acid (HA). They found that more than 70% of the HA was removed from synthetic wastewater, and more than 82% of HA was eliminated from real wastewater. In another application using a combination of algae and G. lucidum, Xu et al. [36] successfully removed the pollutants from synthetic domestic wastewater with 74.41% of COD and 73.95% of total nitrogen (TN) of 74.41% and 79.35%. The WRF was also studied in application to synthetic oil refinery wastewater [37], with the highest percentage achieved being 91%.
4. Conclusions
G. lucidum convincingly reacted with synthetic domestic wastewater in different concentrations to remove COD and ammonia. The best degradation of COD and ammonia had a percentage removal range of 95% to 100% within 30 h of treatment. Based on statistical analysis, the mycoremediation using 100 rpm agitation provided the best results by removing more than 95% COD and ammonia from synthetic wastewater. The oval G. lucidum retained its oval shape after treatment with a slight change in hyphae and colour compared to before treatment. Ganoderma lucidum is a new prospective alternative to wastewater treatment technologies, and current research work is vital for promoting the G. lucidum applications in wastewater.
Author Contributions
Conceptualization, S.M. and W.H.M.W.M.; methodology, Z.M.H. and S.M.; software, T.S.B.A.M.; validation, W.H.M.W.M. and T.S.B.A.M.; formal analysis, S.M.; investigation, S.M.; resources, W.A.A.Q.I.W.-M.; writing—original draft preparation, S.M.; writing—review and editing, Z.M.H. and F.M.-S.; visualization, S.M.; supervision, W.H.M.W.M.; project administration, F.M.-S.; funding acquisition, W.H.M.W.M., W.A.A.Q.I.W.-M. and F.M.-S. All authors have read and agreed to the published version of the manuscript.
Funding
This research was funded by Universiti Kebangsaan Malaysia (UKM), Geran Universiti Penyelidikan (DIP-2022-010) (W.H.M.W.M., Universiti Kebangsaan Malaysia) and Universiti Malaya Others MOHE—Top 100 (IIRG)-IISS Grant (IIRG003A-2020IISS) (W.A.A.Q.I.W.-M., Universiti Malaya).
Institutional Review Board Statement
Not applicable.
Informed Consent Statement
Not applicable.
Data Availability Statement
Not applicable.
Conflicts of Interest
The authors declare no conflict of interest.
References
- Ariffin, M.; Sulaiman, S.N.M. Regulating sewage pollution of Malaysian rivers and its challenges. Procedia Environ. Sci. 2015, 30, 168–173. [Google Scholar] [CrossRef]
- Hassan, H.A.; Abdullah, S.R.S.; Kamarudin, S.K.; Kofli, N.T. Problems of ammonia and manganese in Malaysian drinking water treatments. World Appl. Sci. J. 2011, 12, 1890–1896. [Google Scholar]
- Zinicovscaia, I.; Cepoi, L. Conventional Methods of Wastewater Treatment. In Cyanobacteria for Bioremediation of Wastewaters; Springer: Cham, Switzerland, 2016; pp. 17–30. [Google Scholar]
- Saleem, J.; Shahid, U.; Hijab, M.; Mackey, H.; McKay, G. Production and applications of activated carbons as adsorbents from olive stones. Biomass Conv. Bioref. 2019, 9, 775–802. [Google Scholar] [CrossRef]
- Butler, E.; Hung, Y.T.; Ahmad, M.S.A.; Yeh, R.Y.; Liu, R.L.; Fu, Y. Oxidation pond for municipal wastewater treatment. Appl. Water Sci. 2017, 7, 31–51. [Google Scholar] [CrossRef]
- Samer, M. Biological and Chemical Wastewater Treatment Processes. In Wastewater Treatment Engineering, 1st ed.; InTech: London, UK, 2015. [Google Scholar]
- Batstone, D.J. High Rate Anaerobic Treatment of Complex Wastewater. PhD Thesis, The University of Queensland, Brisbane, Australia, 2000. Available online: https://espace.library.uq.edu.au/view/UQ:10614 (accessed on 17 August 2022).
- Ammary, B.Y. Nutrients requirements in biological industrial wastewater treatment. Afr. J. Biotechnol. 2004, 3, 236–238. [Google Scholar]
- Tabassum, M.; Noor, A.Y.; Suraini, A.A.; Nor’Aini, A.R.; Yee, P.; Shirai, Y.; Mohd, A.H. Turning waste to wealth-biodegradable plastics polyhydroxyalkanoates from palm oil mill effluent–a Malaysian perspective. J. Clean. Prod. 2010, 18, 1393–1402. [Google Scholar]
- Mir-Tutusaus, J.A.; Baccar, R.; Glòria, C.; Sarrà, M. Can white-rot fungi be a real wastewater treatment alternative for organic micropollutants removal? A review. Water Res. 2018, 138, 137–151. [Google Scholar] [CrossRef] [PubMed]
- El Sheikha, A.F. Nutritional Profile and Health Benefits of Ganoderma lucidum “Lingzhi, Reishi, or Mannentake” as Functional Foods: Current Scenario and Future Perspectives. Foods 2022, 11, 1030. [Google Scholar] [CrossRef]
- Wachtel-Galor, S.; Tomlinson, B.; Benzie, I.F. Ganoderma lucidum (“Lingzhi”), a Chinese medicinal mushroom: Biomarker responses in a controlled human supplementation study. Br. J. Nutr. 2004, 2004. 91, 263–269. [Google Scholar] [CrossRef]
- Oke, M.A.; Afolabi, F.J.; Oyeleke, O.O.; Kilani, T.A.; Adeosun, A.R.; Olanbiwoninu, A.A.; Adebayo, E.A. Ganoderma lucidum: Unutilized natural medicine and promising future solution to emerging diseases in Africa. Front. Pharmacol. 2022, 13, 952027. [Google Scholar] [CrossRef] [PubMed]
- Kumar, A.; Chandra, R. Ligninolytic enzymes and its mechanisms for degradation of lignocellulosic waste in environment. Heliyon 2020, 6, e03170. [Google Scholar] [CrossRef]
- Kim, S. Mushroom Ligninolytic Enzymes–Features and Application of Potential Enzymes for Conversion of Lignin into Bio-Based Chemicals and Materials. Appl. Sci. 2021, 11, 6161. [Google Scholar] [CrossRef]
- Selvakumar, S.; Manivasagan, R.; Chinnappan, K. Biodegradation and decolourization of textile dye wastewater using Ganoderma lucidum. Biotech 2013, 3, 71–79. [Google Scholar] [CrossRef] [PubMed]
- Cruz-Morató, C.; Lucas, D.; Llorca, M.; Rodriguez-Mozaz, S.; Gorga, M.; Petrovic, M.; Barceló, D.; Vicent, T.; Sarrà, M.; Marco-Urrea, E. Hospital wastewater treatment by fungal bioreactor: Removal efficiency for pharmaceuticals and endocrine disruptor compounds. Sci. Total Environ. 2014, 493, 365–376. [Google Scholar] [CrossRef]
- Selim, M.T.; Salem, S.S.; Mohamed, A.A.; El-Gamal, M.S.; Awad, M.F.; Fouda, A. Biological Treatment of Real Textile Effluent Using Aspergillus flavus and Fusarium oxysporium and Their Consortium along with the Evaluation of Their Phytotoxicity. J. Fungi 2021, 7, 193. [Google Scholar] [CrossRef] [PubMed]
- Cruz del Álamo, A.; Pariente, M.I.; Alejandra, S.B.; Puyol, D.; Rodríguez, R.; Morales, V.; Bautista, L.F.; Vicente, G.; Melero, J.A.; Molina, R.; et al. Assessment of Trametes versicolor, Isochrysis galbana, and Purple Phototrophic Bacteria for the Removal of Pharmaceutical Compounds in Hospital Wastewater. Adv. Environ. Eng. Res. 2021, 2, 027. [Google Scholar]
- Lucas, D.; Barcelo, D.; Rodríguez-Mozaz, S. Removal of pharmaceuticals from wastewater by fungal treatment and reduction of hazard quotients. Sci. Total Environ. 2016, 571, 909–915. [Google Scholar] [CrossRef]
- Hanafiah, Z.M.; Mohtar, W.H.M.W.; Hasan, H.A.; Jensen, H.S.; Klaus, A.; Wan-Mohtar, W.A.A.Q.I. Performance of wild- Serbian Ganoderma lucidum mycelium in treating synthetic sewage loading using batch bioreactor. Sci. Rep. 2019, 9, 16109. [Google Scholar] [CrossRef]
- Taufek, N.M.; Harith, H.H.; Rahim, M.H.A.; Ilham, Z.; Rowan, N.; Wan-Mohtar, W.A.A.Q.I. Performance of mycelial biomass and exopolysaccharide from Malaysian Ganoderma lucidum for the fungivore red hybrid Tilapia (Oreochromis sp.) in Zebrafish embryo. Aquac. Rep. 2020, 17, 100322. [Google Scholar] [CrossRef]
- Wan-Mohtar, W.A.A.Q.I.; Young, L.; Abbott, G.M.; Clements, C.; Harvey, L.M.; McNeil, B. Antimicrobial properties and cytotoxicity of sulfated (1, 3)-β-D-glucan from the mycelium of the mushroom Ganoderma lucidum. J. Microbiol. Biotechnol. 2016, 26, 999–1010. [Google Scholar] [CrossRef]
- Supramani, S.; Jailani, N.; Ramarao, K.; Zain, N.A.M.; Klaus, A.; Ahmad, R.; Wan-Mohtar, W.A.A.Q.I. Pellet diame ter and morphology of European Ganoderma pfeifferi in a repeated-batch fermentation for exopolysaccharide production. Biocatal. Agric. Biotechnol. 2019, 19, 101118. [Google Scholar] [CrossRef]
- Method 8000, 05/2021, Edition 12, Oxygen Demand, Chemical, USEPA Reactor Digestion Method, HACH, Kuala Lumpur, Malaysia. Available online: https://www.hach.com/asset-get.download.jsa?id=7639983816 (accessed on 26 April 2022).
- Method 8155, 09/2015, Edition 10, Nitrogen ammonia, Salicylate method, HACH, Kuala Lumpur, Malaysia. Available online: https://ca.hach.com/asset-get.download.jsa?id=7639983745 (accessed on 26 April 2022).
- Hanafiah, Z.M.; Mohtar, W.H.M.W.; Hasan, H.A.; Jensen, H.S.; Klau, A.; Sharil, S.; Wan-Mohtar, W.A.A.Q.I. Ability of Ganoderma lucidum mycelial pellets to remove ammonia and organic matter from domestic wastewater. Int. J. Environ. Sci. Technol. 2022, 19, 7307–7320. [Google Scholar] [CrossRef]
- Sankaran, S.; Khanal, S.K.; Jasti, N.; Jin, B.; Pometto, A.L., III. Leeuwen, JHV Use of filamentous fungi for wastewater treatment and production of high value fungal byproducts: A review. Crit. Rev. Environ. Sci. Technol. 2010, 40, 149. [Google Scholar] [CrossRef]
- Dalecka, B.; Oskarsson, C.; Juhna, T.; Rajarao, G.K. Isolation of fungal strains from municipal wastewater for removal of pharmaceutical substances. Water 2020, 12, 524. [Google Scholar] [CrossRef]
- Seth, M.; Chand, S. Biosynthesis of tannase and hydrolysis of tannins to gallic acid by Aspergillus awamori-optimisation of process parameter. Process Biochem 2000, 36, 39–44. [Google Scholar] [CrossRef]
- Ibrahim, D.; Weloosamy, H.; Lim, S.H. Effect of agitation speed on the morphology of Aspergillus niger HFD5A-1 hyphae and its pectinase production in submerged fermentation. World J. Biol. Chem. 2015, 6, 265–271. [Google Scholar] [CrossRef] [PubMed]
- Lueangjaroenkit, P.; Teerapatsakul, C.; Chitradon, L. Morphological Characteristic Regulation of Ligninolytic Enzyme Produced by Trametes polyzona. Mycobiology 2018, 6, 396–406. [Google Scholar] [CrossRef] [PubMed]
- Schmideder, S.; Barthel, L.; Müller, H.; Meyer, V.; Briesen, H. From macro- to micromorphological properties of filamentous fungal pellets. Chem. Ing. Tech. 2020, 92, 1182–1183. [Google Scholar] [CrossRef]
- Zahmatkesh, M.; Spanjers, H.; Lier, J.B.V. A novel approach for application of white rot fungi in wastewater treatment under non-sterile conditions: Immobilisation of fungi on sorghum. Environ. Technol. 2018, 39, 2030–2040. [Google Scholar] [CrossRef] [PubMed]
- Lucas, D.; Castellet-Rovira, F.; Villagrasa, M.; Badia-Fabregat, M.; Barceló, D.; Vicent, T.; Caminal, G.; Sarràb, M.; Rodríguez-Mozaza, S. The role of sorption processes in the removal of pharmaceuticals by fungal treatment of wastewater. Sci. Total Environ. 2018, 610–611, 1147–1153. [Google Scholar] [CrossRef] [PubMed]
- Xu, J.; Wang, X.; Sun, S.; Zhao, Y.; Hu, C. Effects of influent C/N ratios and treatment technologies on integral biogas upgrading and pollutants removal from synthetic domestic sewage. Sci. Rep. 2017, 7, 10897. [Google Scholar] [CrossRef] [PubMed]
- Werkneh, A.A.; Rene, E.R.; Lens, P.N.L. Simultaneous removal of selenite and phenol from wastewater in an upflow fungal pellet bioreactor. J. Chem. Technol. Biotechnol. 2017, 93, 1003–1011. [Google Scholar] [CrossRef]
Disclaimer/Publisher’s Note: The statements, opinions and data contained in all publications are solely those of the individual author(s) and contributor(s) and not of MDPI and/or the editor(s). MDPI and/or the editor(s) disclaim responsibility for any injury to people or property resulting from any ideas, methods, instructions or products referred to in the content. |
© 2023 by the authors. Licensee MDPI, Basel, Switzerland. This article is an open access article distributed under the terms and conditions of the Creative Commons Attribution (CC BY) license (https://creativecommons.org/licenses/by/4.0/).